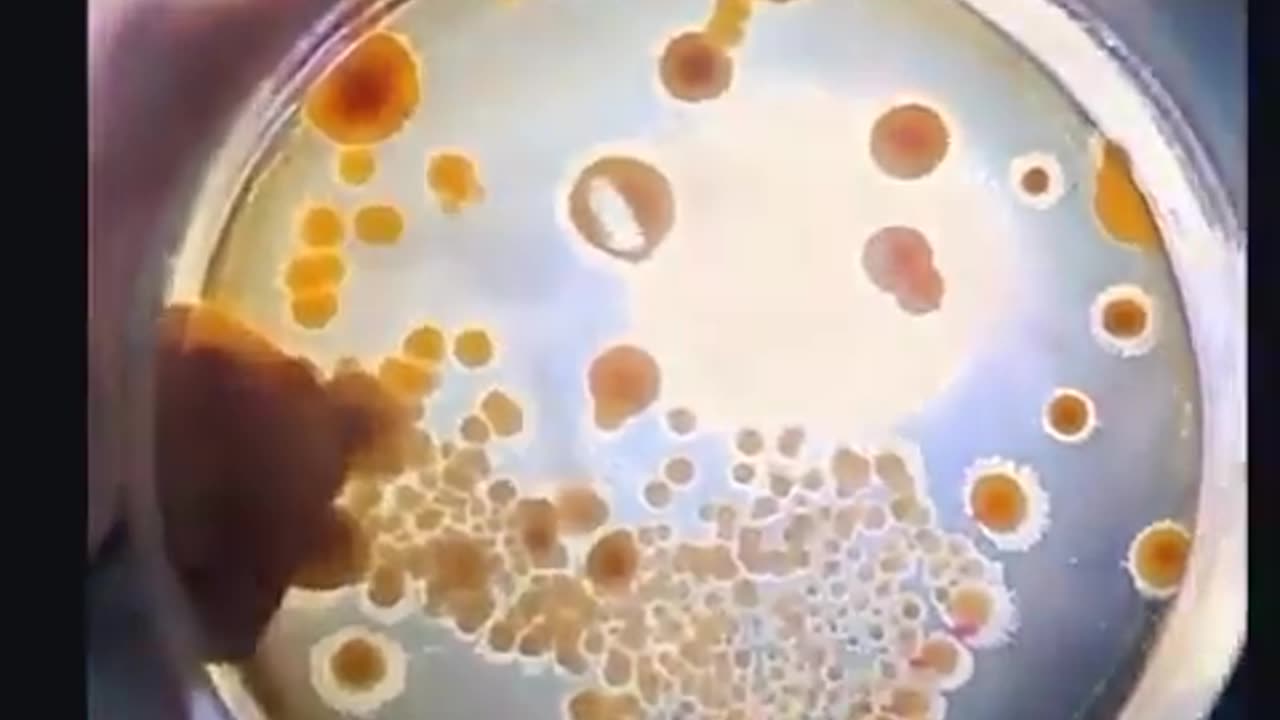
New Research Exposes a Hidden Danger in Your Home: Wi-Fi Routers May ...

Premium Only Content
This video is only available to Rumble Premium subscribers. Subscribe to
enjoy exclusive content and ad-free viewing.
New Research Exposes a Hidden Danger in Your Home: Wi-Fi Routers May ...
4 days ago
85
New Research Exposes a Hidden Danger in Your Home: Wi-Fi Routers May Be Supercharging Toxic Mold
Household mold, usually harmless, can become 600 times more toxic when exposed to Wi-Fi signals. The electromagnetic fields (EMF) trigger mold’s survival mode, causing it to release mycotoxins—its chemical defense weapons—at alarming levels.
Victims report severe symptoms: swollen eyes, hair loss, and debilitating illness, with some scoring 8.5 out of 10 on toxicity scales. The culprit? Aspergillus niger, a common mold that turns aggressive under EMF exposure. Even costly remediation won’t stop the cycle—your Wi-Fi could be reactivating the threat daily.
This isn’t an isolated case. It’s happening in homes nationwide. Are you at risk?
Loading 1 comment...
-
 1:56:20
1:56:20
Tucker Carlson
5 hours agoIt’s Time to Decide: America First or Lindsey Graham’s Psychosexual Death Cult?
86.1K361 -
 LIVE
LIVE
SpartakusLIVE
8 hours agoBattlefield 6 - REDSEC || ARC Raiders Later? || Anybody Want Warzone???
520 watching -
 DVR
DVR
Alex Zedra
4 hours agoLIVE! Spooky Games tn
40.8K2 -
 2:58:21
2:58:21
I_Came_With_Fire_Podcast
15 hours agoThe Normalization of Political Violence | Right Wing In-Fighting | China Chooses China
29.8K9 -
 2:37:06
2:37:06
PandaSub2000
10 hours agoLIVE 10:30pm ET | BUZZ TRIVIA with Chat!
29.5K2 -
 1:13:58
1:13:58
ThisIsDeLaCruz
3 hours ago $0.01 earnedWhat Fans Never Hear: Pearl Jam’s Audio Engineer Tells His Story
22.1K5 -
 1:39:58
1:39:58
Glenn Greenwald
7 hours agoWhy Did Zohran Win & What Does it Mean? Plus: Dick Cheney, "Hero of the Resistance" | SYSTEM UPDATE #543
134K85 -

This is the Ray Gaming
4 hours agoRAYmember RAYmember the 5th of November | Rumble Premium Creator
14.9K6 -
 1:44:39
1:44:39
vivafrei
7 hours agoArctic Frost is Bigger Scandal than you Think!! Live with Former Green Beret Ivan Raiklin!
61K57 -
 2:29:57
2:29:57
Turning Point USA
6 hours agoTPUSA Presents This Is the Turning Point Tour LIVE with Eric and Lara Trump at Auburn University!
54.6K15